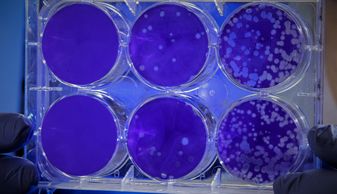

For more than half a century, activated sludge has been the dominant approach to water restoration. It's expensive, and uses harmful chlorinated compounds, producing large amounts of waste sludge and nutrient discharges. It's time for a new approach.
The Rigby System uses direct current to process inorganic and organic compounds, purifying water and minimizing ecological impact. Treatment occurs at the molecular level, without bacteria or chemicals, delivering clean, safe water in minutes. The Electro-Chemistry reactor is simple, housed in a trailer that can be pulled by a commercial pickup truck and parked alongside most water processing facilities.
Maintenance of the equipment is minimal, cleaning is easy and energy consumption is cost-effective. Adjustable power settings make it possible to target specific contaminants, and economical reactor materials can be purchased at a local hardware store.
What sets us apart:
Chemistry + Electrical
Like our name, the system uses electricity to remove organic and inorganic compounds by breaking down molecular and ionic bonds:
Organic Compounds
Organic contaminants are typically found in domestic sewage and industrial wastewater, and when they enter the water stream, bacteria break down organic compounds, stripping dissolved oxygen out the of water. Using direct current breaks molecular bonds, producing smaller, less troublesome molecules, often just carbon dioxide and water.
Inorganic Solids
Inorganic solids pollute water by blocking out sunlight, silting up the stream beds and covering sediment organisms. By applying direct current electrons (neutralizing negative surface charges), inorganic solid particles are separated from the water.
Read more below on how the Rigby System treats specific contaminants:

In two test programs at the Gold King Mine in Colorado and for Milligan Brand in New Mexico, EC successfully removed dissolved iron. In both cases, the pH of the groundwater was 5.0, dissolving iron from the rock strata, with raw water iron concentration of 20.0 parts per million. The application of electrical current resulted in the oxidation and then precipitation with an effluent iron concentration of 0.1 parts per million.
As well as removing contaminants, the Rigby System kills coliform bacteria. 100% kill was achieved in every test application.

To address animal slaughtering, further processing or cooking and packaging in the poultry, beef, pork or seafood industries, EC can be used instead of chemicals ahead of a dissolved air flotation clarifier. The electro-chemical process results in a cleaner and denser rendered byproduct.

Domestic sewage and numerous types of industrial waste are contaminated with nutrients, including nitrogen. Through nitrification, ammonia is oxidized to nitrate; nitrate can be further reduced to nitrogen gas through the process of denitrification. The EPA defines the limits of technology for biological denitrification as 3.0 parts per million.
EC successfully removes 99% of both ammonia and nitrate. Tests on secondary clarifier effluent also show a reduction of nitrate from between 10 – 20 parts per million to between 0.1 – 0.2 parts per million using EC technology.
Phosphorous removal has been successfully tested at several wastewater treatment plants and at numerous industrial facilities, including Coca-Cola’s Atlanta base beverage facility. Phosphorous was efficiently and almost completely removed through the release of iron in either the ferric or ferrous forms, which then combined with the phosphate ions to form a precipitate.

Disposal of activated sludge from wastewater treatment plants is one of the biggest challenges in water management today.
Our test results demonstrate that the bacterial cells are lysed, releasing bound water while simultaneously neutralizing cell surface charges. Compared to conventionally conditioned sludge, using an electro-chemical application results in rapidly settling sludge. When pressed, this sludge reduces to twice the density in half the time (without the use of polymers or other chemicals).
.jpg/:/cr=t:0%25,l:0%25,w:100%25,h:100%25/rs=w:388,h:194,cg:true)
In two definitive studies, EC effectively treated graywater to produce reuse-quality standards.
In the UK, the Ministry of Defence selected EC as its preferred technology after trials on domestic laundry, sink and shower water. EC produced treated drinking water that met NATO standards for emergency field conditions and was palatable for drinking at the Climate Day demonstration.
In Butler’s Laundry trials in Dubai, EC effectively removed dirt and detergents to levels for water reuse in the laundry. Cost savings in purchased water and reduced municipal costs for discharged wastewater meant a return on investment in under two years.

Electro-chemical technology has been used extensively to treat wastewater in the oil and gas production industry. EC has been very effective in removing petroleum oils and solids from driller mud and flowback water (while also reducing hardness and scaling effects). In addition, EC can almost instantaneously clean frack water. With our partner, Electro-Chemistry Texas, Inc., EC intends to sell new Rigby System units to oil and gas drillers, and provide long-term maintenance services in the Texas Permian Basin.

Electro-chemical technology is effective in removing heavy metals from water. In the trials at the Bureau of Land Management site in Silverton, CO, in addition to removing iron, EC removed lead, chromium and copper to non-detect levels. At the Atlanta Coca-Cola beverage plant, copper was removed from the nanofiltration reject water; and at Gulf Chemical in Corpus Christi, TX, molybdenum was removed from process water.
EC also removes selenium and arsenic.

The task of cleaning up the oily bilge and ballast from incoming ships and cruise liners was one of the earliest goals of Electro-Chemistry. Currently, contaminated discharge is handled by municipal sewage systems, with high costs and a huge environmental impact. The Rigby System has the potential to transform ports around the world and reduce wastewater processing resources.
Copyright © 2020 Electro-Chemistry - All Rights Reserved